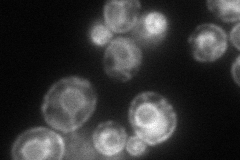
YOL031C
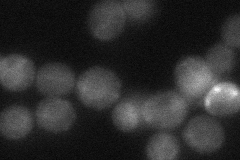
YOL031C
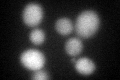
YOL031C

View description
Nucleotide exchange factor for the endoplasmic reticulum (ER) lumenal Hsp70 chaperone Kar2p, required for protein translocation into the ER; homolog of Yarrowia lipolytica SLS1; GrpE-like protein
Localization:
Intensity:
Fold change:
Significance:
-
C’ GFP library in SD

cytosol24.81 -
N' NOP1pr-GFP in SD

ER131.465 -
N' TEF2pr-mCherry in SD
ER,vacuole88.7646 -
N' NATIVEpr-GFP in SD
ambiguous31.5019 -
N' TEF2pr-VC and Cyto-VN in SD

#N/A0 -
C’ GFP library in SD+DTT
cytosol46.181.86Yes -
C’ GFP library in SD+H2O2

cytosol24.971No -
C’ GFP library in Starvation Media

cytosol20.260.81No -
C’ GFP library on the background of Pup2-DaMP

cytosol -
C’ GFP library on the background of CCT mutant

cytosol28.4791.14765No
